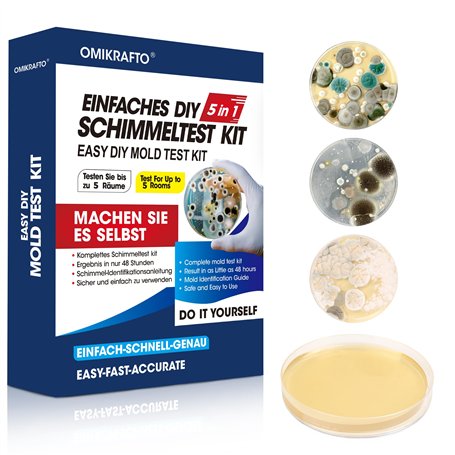
Kit de test de moisissure pour la maison - Test de moisissure pour 5 pièces - Test rapide de l'air ambiant pour la qualité de l'

Kit de test de moisissure pour la maison - Test de moisissure pour 5 pièces - Test rapide de l'air ambiant pour la qualité de l'
Le kit de test de moisissure pour la maison OMIKRAFTO est un outil complet pour évaluer la qualité de l'air intérieur.
- Test de moisissure pour 5 pièces : Contrôle détaillé de la qualité de l'air dans toute la maison.
- Tests intérieurs polyvalents : Adapté pour les environnements intérieurs variés.
- Trois méthodes de test pour une analyse complète : Détection des moisissures visibles et invisibles.

Livraison en Martinique tout compris

Retours et SAV simplifiés

Garantie Isleden
Description
Kit de test de moisissure pour la maison - Test de moisissure pour 5 pièces - Test rapide de l'air ambiant pour la qualité de l'
Le kit de test de moisissure OMIKRAFTO est un outil complet pour évaluer la qualité de l'air dans votre maison. Il comprend 5 boîtes de pétri d'agar, 10 cotons-tiges et un guide d'identification détaillé. Ce kit polyvalent permet un contrôle détaillé de la qualité de l'air et identifie différents types de moisissures, assurant des résultats précis et fiables pour votre tranquillité d'esprit.
Caractéristiques techniques principales

- Détection polyvalente : Contrôle de la qualité de l'air intérieur et des surfaces
- Trois méthodes de test : Test de qualité de l'air, échantillonnage des climatiseurs, test de surface
- Résultats rapides : Détection visible de la moisissure en 48 heures
Points forts de Kit de test de moisissure pour la maison

- Contrôle complet : Testez la présence de moisissures dans différents environnements intérieurs
- Résultats précis : Obtenez des informations claires pour une action rapide
- Sécurité garantie : Protégez votre famille et assurez un environnement sain
Pourquoi choisir Kit de test de moisissure pour la maison ?
Ce kit de test de moisissure est un investissement essentiel pour assurer la qualité de l'air dans votre maison. Avec sa polyvalence, sa facilité d'utilisation et ses résultats rapides, il vous offre la tranquillité d'esprit nécessaire pour protéger votre famille contre les risques liés à la moisissure. Ne prenez aucun risque pour votre santé et celle de vos proches, optez pour le kit de test de moisissure OMIKRAFTO dès aujourd'hui.
Achetez en ligne sur Isleden pour une livraison rapide et sécurisée. Profitez d’une expérience d’achat en toute confiance avec des garanties et un service de qualité.
Caractéristiques
Livraison à la Martinique
Notre priorité est votre satisfaction et nous mettons tout en œuvre pour vous apporter un service irréprochable.
|
|
|
Grâce à sa logistique ultra-performante, grâce à ses partenaires locaux, Isleden apporte votre commande directement chez vous ou dans votre boîte aux lettres si vous n'êtes pas là.
Si la valeur est importante, le colis sera remis contre signature. En cas d'absence, si votre colis est trop volumineux, il sera mis en instance dans votre bureau de Poste le plus proche.
Commandez depuis votre canapé et faites vous livrer à domicile. C'est aussi simple que ça !
 |
|
Chaque jour, Isleden ajoute à son catalogue de nouveaux fournisseurs et des milliers de produits. Revenez régulièrement pour trouver la perle rare.
Dès la commande passée, nous mettons tout en œuvre afin de réduire le temps de livraison. Nos transporteurs et partenaires locaux font le maximum pour vous apporter rapidement votre commande, dans les meilleures conditions.
Que vous commandiez un téléphone mobile, une perceuse ou un ordinateur portable, nous attachons une grande importance à ce que vous profitiez rapidement de votre achat.
 |
|
Fini la galère des achats sur les sites qui ne livrent pas directement, rapatriés comme on peut, sans retour possible ni SAV, et parfois avec une ardoise à l'arrivée qu'on avait pas prévu.
Chez Isleden il n'y a pas de taxes ni de frais de douane. Nos prix sont tout compris et vous n'avez rien à payer à l'arrivée. Vous avez la possibilité de nous retourner votre produit sous 14 jours et le SAV est bien sûr pris en charge.
Tous nos produits sont garantis et bénéficient du service premium Isleden. en cas de panne, le formulaire disponible sur le site permet faciemnt d'enregistrer son SAV qui sera alors traité dans les meilleurs délais.